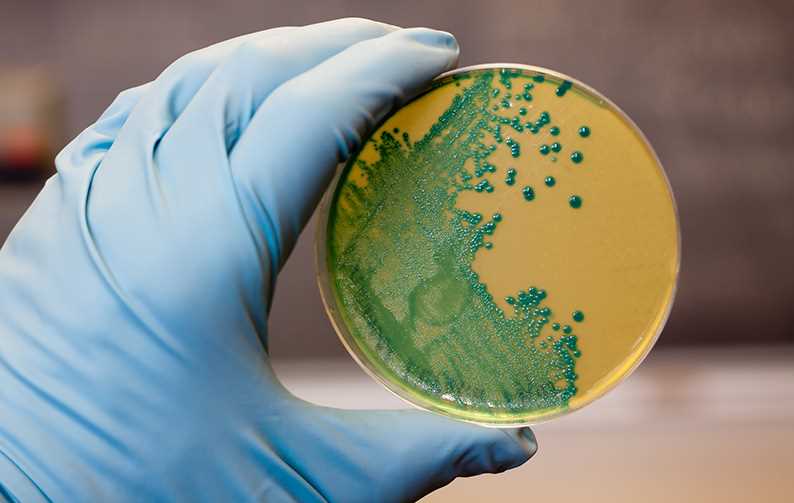

Patogenní mikroorganismy a Listeria Monocytogenes
Patogenní mikroorganismy a Listeria Monocytogenes
Mikroorganismy nežijí jen volně kolem nás, ale pronikají také do organismu, kde začnou přijímat látky pro svůj metabolizmus a svádějí s tímto organismem boj o přežití.
Výsledkem tohoto boje může být onemocnění lidí, zvířat nebo rostlin. Takovým mikroorganismům říkáme patogenní (choroboplodné). Některé kmeny vyvolávají onemocnění se smrtelným, jiné s velmi mírným průběhem. Patogenita mikroorganismů se projevuje dvojím účinkem. Jeden účinek je ten, že mikroorganismus dovede vytvořit velmi nebezpečný toxin. Druhý účinek, že mikroorganismus pronikne do organismu a začne se v něm množit. Sám nevytváří toxiny, ale škodí a vyvolává onemocnění svým rozmnožováním na úkor lidské tkáně. V prvním případě je tedy mikroorganismus patogenní svou toxicitou a v druhém svou virulencí.
Mezi významného potravinového patogena řadíme bakterii Listeria monocytogenes, která představuje vážné riziko pro zdraví člověka kvůli vysoké úmrtnosti.
Ve svém posledním reportu o zoonózách Bezpečnostní úřad pro bezpečnost potravin (EFSA) konstatoval, že v roce 2022 se počet případů onemocnění listeriózou v EU zvýšil o 15,9 % ve srovnání s rokem 2021. Dále v reportu úřad uvedl, že počet úmrtí v roce 2022 v důsledku alimentárních nákaz a způsobených bakterií L. monocytogenes byl v Evropě jeden z největších za posledních 10 let.
Evropská Komise chystá změny v hodnocení bezpečnostních kritérií při kontaminaci potravin určených k přímé spotřebě bakterií L. monocytogenes. Cílem této iniciativy je sladit pravidla EU s mezinárodními normami „Codex alimentarius“, pokud jde o přijatelnou úroveň kontaminace určitých kategorií potravin určených k přímé spotřebě prodávaných na trhu EU bakterií L. monocytogenes.
Riziko nákazy listeriózou prostřednictvím potravin je ovlivněno jak individuální vnímavostí jedince, tak i schopností kontaminované potraviny podporovat růst bakterie. Kojenci a osoby s oslabeným imunitním systémem jsou vysoce citliví na listerii a nemohou být vystaveny tomuto patogenu v jakékoliv koncentraci. U zdravých osob byl stanoven limit 100 KTJ/g. Nad tento limit je požití kontaminované potraviny potenciálně zdraví škodlivé.
Aby byla zaručena stejná úroveň ochrany veřejného zdraví od výroby až po distribuci potravin určených k přímé spotřebě, které podporují růst L. monocytogenes, jiné než pro kojence a pro zvláštní lékařské účely, bezpečnostní kritérium „L. monocytogenes nezjištěna v 25 g“ by se mělo vztahovat na celou dobu, kdy jsou tyto potraviny uváděny na trh během jejich doby údržnosti, a u potravin, u nichž provozovatel potravinářského podniku, který je vyrábí, není schopen prokázat, že limit 100 cfu/g nebude překročen po celou dobu jejich údržnosti.
Nařízení (ES) č. 2073/2005, příloha I, kapitola 1 (Kritéria bezpečnosti potravin), položka 1.2 se nahrazuje tímto:
Kategorie potravin | Mikroorganismy/jejich toxiny, metabolity | Plán odběru vzorků | Limity | Analytická referenční metoda | Fáze, na niž se kritérium vztahuje | ||
n | c | m | M | ||||
1.2 Potraviny určené k přímé spotřebě, které podporují růstL. monocytogenes,jiné než pro kojence a pro zvláštní léčebné účely | Listeria monocytogenes | 5 | 0 | 100 KTJ/g (*) | 100 KTJ/g (*) | produkty uvedené na trh během doby údržnosti | |
5 | 0 | Nezjištěno ve 25 g (***) | EN/ISO 11290-1 | produkty uvedené na trh během doby údržnosti |
* Toto kritérium platí, pokud je výrobce schopen prokázat, že výrobek nepřekročí limit 100 KTJ/g po celou dobu údržnosti.
** 1 ml inokula se naočkuje na Petriho misku o průměru 140 mm nebo na tři Petriho misky o průměru o průměru 90 mm
*** Toto kritérium platí, pokud provozovatel potravinářského podniku není schopen prokázat, že výrobek nepřekročí limit 100 KTJ/g po celou dobu údržnosti.
Interpretace výsledku se nahrazuje tímto:
L. monocytogenes v potravinách určených k přímé spotřebě, které podporují růst L. monocytogenes, pokud provozovatel potravinářského podniku, který je vyrábí není schopen prokázat, že výrobek nepřekročí limit 100 KTJ/g po celou dobu údržnosti:
vyhovující, pokud všechny zjištěné hodnoty poukazují na nepřítomnost této bakterie,
nevyhovující, pokud je přítomnost této bakterie určena v kterékoli jednotce vzorku.
Celé znění návrhu změny najdete zde.
Změny v Nařízení vstoupí v platnost 1. ledna 2026.
Pro více informací k jednotlivým analýzám a zaslání nabídky služeb kontaktujte náš zákaznický servis na tel: +420 226 226 998 nebo e-mailem: czsupport.food@alsglobal.com.